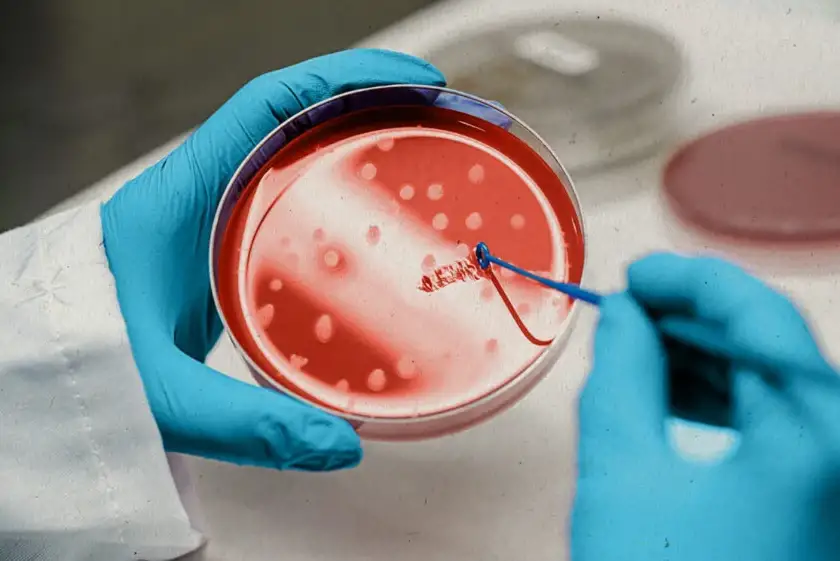

Welcome to SZLINE Dermatology & Aesthetic Surgery
Always Get The Best Result.
SZLINE Dermatology & Aesthetic Surgery in Busan, South Korea
We’re here to help you achieve healthy, radiant skin with confidence. Whether you’re interested in dermatology treatments, aesthetic procedures, or simply want to learn more about our services, our team is ready to assist you.

Discover why patients choose SZLINE Dermatology & Aesthetic Surgery—where medical expertise meets artistry in beauty.
Read real patient reviews of SZLINE Dermatology & Aesthetic Surgery. Discover trusted experiences in skin care, anti-aging, and cosmetic treatments.
Make An Appointment
Book a consultation with SZLINE Dermatology & Aesthetic Surgery to receive personalized treatment plans, expert guidance, and attentive care tailored to your needs.


Excellence in Skincare and Aesthetic Surgery

4.8/5
1860 Reviews
4.6/5
1630 Reviews
4.7/5
2100 Reviews
Our Expertise
SZLINE Dermatology & Aesthetic Surgery is a reputable clinic located in Busan, South Korea, specializing in a comprehensive range of skin and aesthetic treatments.
Liposuction (Body Contouring) | Safe & Precise Fat Removal
Breast Enhancement | Natural Augmentation & Shaping
Thread Lift | Non-Surgical Face Lift & Skin Tightening
Skin Treatments | Laser, Rejuvenation & Anti-Aging Care
Non-Surgical Aesthetic Treatments | Botox & Fillers
Stem Cell Therapy | Advanced Regenerative Treatment
Why People Trust Us
High Quality Lab
Advanced lab technology ensuring precision, safety, and trusted results.
Unmatched Expertise
Expert care backed by years of clinical excellence.
Precise Result
Accurate treatments tailored for natural, consistent outcomes.
Qualified Staff
Board-certified professionals with advanced clinical expertise.
Breast Augmentation with Implants
What People Say About Us
Our patients’ experiences reflect the personalized care and trust we are proud to deliver at SZLINE Dermatology & Aesthetic Surgery.

Jian Lee, China
Dermatology skin clinic is spotless, the staff is welcoming, and the doctors are true experts. After just one visit, I noticed visible improvements in my skin, and I can’t wait to continue my sessions.
Meet Our Professionals


Dr. Choi Joo Taek
SZLINE Medical Member

Dr. Lim Jung Soo
SZLINE Medical Member

Dr. Bae Jin Hyung
SZLINE Medical Member

Dr. Cho Ji Hee
SZLINE Medical Member

Dr. Kim Jong Hyun
SZLINE Medical Member
EXCELLENTTrustindex verifies that the original source of the review is Google. 실리프팅이랑 리쥬란 시술 했어요 데스크 직원, 상담 실장님, 수술방 선생님들까지 모두 너무 친절했어요 다음에 또 리프팅 할거에요Posted onTrustindex verifies that the original source of the review is Google. 친절하고 가격이 저렴합니다Posted onTrustindex verifies that the original source of the review is Google. 진짜 중요한 약속 앞두고 급하게 예약해서 다녀왔어요‼️왜 진작 안 왔나 싶을 정도로 피부 컨디션이 확 올라왔어요❣️ 시술 끝나고 거울 봤는데 진심 속광이 올라와서 만족만족ㅎㅎ 화장하고 난 후에도 얼굴에 광이 장난아니에여‼️ 요즘 주변에서 피부 좋아졌다는 소리 많이 듣고 살아여(งᐛ)ว (งᐖ ) 여러분들🙌🏻이제 봄이잖아여〰️ 광채관리 고민하시는 분들 강추입니다‼️ 다음 달에 또 가려구 예약압아버렸지 모에여😊Posted onTrustindex verifies that the original source of the review is Google. 요즘 레디어스가 유명하길래 받으러 가봤어요! 선생님들 다 친절하시고 설명도 잘 해주셨어요 ㅎㅎ 피부결도 매끈매끈해지고 피부가 탱탱해졌어요! 만족합니다Posted onTrustindex verifies that the original source of the review is Google. 가성비 좋은 피부과Posted onTrustindex verifies that the original source of the review is Google. 제가 몇년동안 다니는곳입니다 수술 시술 다 잘합니다 지흡 진짜 강추드려요 집이랑 좀 멀어도 뭊조건 서면 쉬즈라인 가요 원장님들 꼼꼼하게 니즈 파악 잘하시고 정말 잘 봐주십니다 직원님들도 친절하셔서 갈때마다 기분 좋아요 그리고 필요없는 시술 강요도 안해요 실장님께서 딱필요한거만 알려주셔서 너무 좋아요 서면점 쉬즈라인 사랑해요♥️Posted onTrustindex verifies that the original source of the review is Google. 친절하고 시술도 꼼꼼히 해주시고 좋아요Posted onTrustindex verifies that the original source of the review is Google. 정말 저렴하고 좋아요! 직원들 엄청 친절합니다 ㅎPosted onTrustindex verifies that the original source of the review is Google. 여기 넘 친절하고 시술도 만족입니다 여기만 꾸준히 찾게되네요~ 굳굳Posted onTrustindex verifies that the original source of the review is Google. 他の病院より値段が高いまのに、実力も説明もたりない。サービスがひどい。

Contact SZLINE Dermatology & Aesthetic Surgery in Busan, South Korea. We’re here to help you achieve healthy, radiant skin with confidence. Whether you’re interested in dermatology treatments, aesthetic procedures, or simply want to learn more about our services, our team is ready to assist you.
SZLINE in Busan Blog
Proven & Advanced Non-Surgical Aesthetic Treatments in Busan Korea for Natural, Youthful Results (2026 Guide)
Ultimate Busan Thread Lifting Longevity Guide: Proven Ways to Achieve Longer-Lasting Facial Lifting Results
Powerful & Proven Advanced Anti-Aging Treatments in Busan, Korea for Natural, Youthful Results (2026 Guide)




Address
74 Seomyeon-ro, Busanjin District, Busan
International Call
+82-51-802-2255
Email Us
szline2016@naver.com